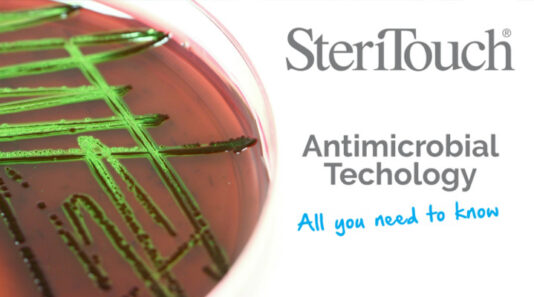

Spur®️shelving is renowned for its products with Steel-Lok considered the best in the market for wall mounted shelving. It is strong, durable, resilient and timeless. What many do not understand is that it is also an eco product.
At the factory then based in Great Torrington, Devon we had transformed powder coating efficiency and reduced energy consumption dramatically with changes in pretreatment, process and procedure. That lead us to the next stage which was the powder we used.
We needed a powder that would deliver key requirements and at the very least be cost neutral. We had problems with opacity with our main supplier causing us to coat thick or on occasion paint twice. We wanted to add Steritouch®️ for our medical clients. We wanted the benefits of using an epoxy polyester powder produced to the unique Spur Frost White colour. It had to be hard wearing and get into the nooks and crannies of our products. Finally it had to be a low bake. We had already cut temperature from 220 to 180 but wanted to go lower.
We chose Thermaset due to the amazing work that their lab achieved. They came up with a powder that enabled us to halve the thickness of the film with a powder that we were able to coat at temperatures as low as 140 degrees on many of our products. It is hardwearing and resilient with a perfect match to Spur®️ from the 1950’s with the benefit of Steritouch®️ technology. Other companies had tried and failed they just did not get it right. The products were fickle and gave a textured finish or did not achieve even the quoted bake.
So what were the benefits of using Thermaset low bake. Well from a cost point of view we ran neutral however as we were the only low bake customer at the time the materials were bought in just for us; that has changed with minimal cost differential between low and high bake. Our energy cost reduced dramatically, we were able to reduce film thickness and use less powder. We have never since had to re-coat due to opacity issues. But one of the biggest changes was operator fatigue. Doing long days hanging at up to 24 items a minute per person in high temperatures, fatigue was an issue. Changing temperature transformed environmental conditions. Output increased and the line had fewer stoppages as people made less mistakes but were also happier. There are many benefits with very real savings to be gained now this is mainstream technology. Oh and there is the little matter of global warming too.
I highly recommend Thermaset low bake powders and their lab team to get you what your business needs.
Peter Sully